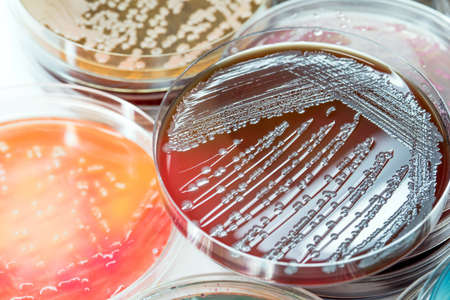
Bacterial culture growth on selective media.Gram positive and gram negative growth.の写真素材

写真素材 - Bacterial culture growth on selective media.Gram positive and gram negative growth.
作品情報
Bacterial culture growth on selective media.Gram positive and gram negative growth.
- ID:99439092
- 作品種別:写真
- 作者名:Sirirat Makprasert
キーワード
- Media
- Salmonela
- Vibrio
- agar
- air
- aureus
- background
- bacteria
- bacterial
- bacterium
- biology
- biotechnology
- black
- blood
- cell
- colony
- color
- culture
- danger
- diagnostic
- disc
- fecal
- food
- growth
- health
- healthcare
- hygiene
- isolate
- isolated
- isolation
- lab
- laboratory
- medical
- medicine
- medium
- micro
- microbe
- microbiology
- pathogen
- pathogens
- petri
- plate
- plates
- red
- research
- risk
- safety
- science
- scientific
- shigella
- streak
- test
- treat
- urine
- yellow
類似作品
petri dish with...
Two Petri dishe...
close-up of vib...
A tray filled w...
close-up of pet...
Petri dishes co...
petri dish with...
The evolution o...
The mesmerizing...
microbial cultu...
Futuristic Petr...
Bacterial growt...
Backgrounds of ...
close up of pet...
A detailed view...
Bacterial colon...
Multiple Petri ...
An overhead sho...
Colorful petri ...
Word biohazard ...
Close up petri ...
Mitosis in earl...
Colorful variet...
Colorful variet...
Laboratory tech...
Infectious Bact...
Laboratory tech...
Petri dishes wi...
A petri dish fi...
close-up of vib...
petri dish with...
A close-up of a...
Gloved hand hol...
Bacterial growt...
Hand in blue gl...
Close up petri ...
Test tubes with...
A mesmerizing t...
microbial cultu...
Various types o...
A petri dish te...
Petri plate wit...
Hold your glove...
Gloved Hand of ...
Backgrounds of ...
Vibrio parahaem...
Laboratory tabl...
Scientist's han...
Close-up detail...